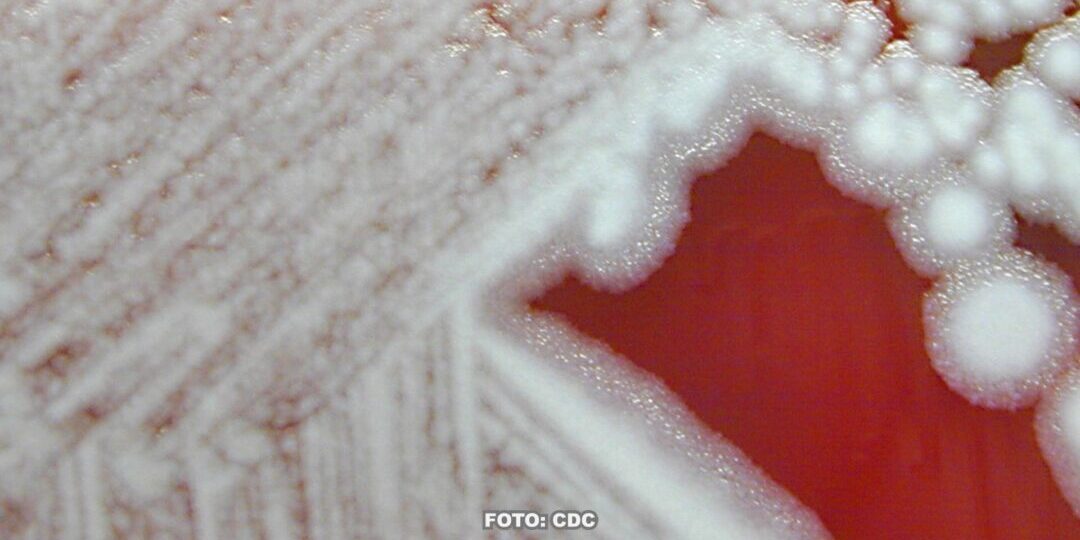

Transkript:
Mit „Expedition in die Forschung“ – unserem Podcast in Vorbereitung – erkunden wir die Forschungslandschaft und deren Bewohner. Aber die Auswahl ist groß! Wo soll es hingehen?
Wir hören ja ständig von Mutanten, in letzter Zeit, aber nicht nur Viren können durch evolutionäre Vorgänge unserem Immunsystem und Medikamenten entgehen. Bakterien passen sich nämlich genauso an unsere Antibiotika an. Es entstehen sogenannte multiresistente Stämme, also Bakterien, gegen die nur noch wenige Antibiotika überhaupt helfen.
Ein neuer Ansatz macht sich jetzt einen anderen Feind der Bakterien zunutze: Viren. Bakteriophagen – übersetzt „Bakterienfresser“ – heißen die Viren, die sich auf Bakterien spezialisiert haben
InfectoGnostics Forschungscampus Jena meldet, dass es Ihnen und ihren Partnern gelungen sei, einen Viren-Cocktail zu züchten, der gegen über 100 multiresistente Bakterienstämme wirksam ist.
Willst Du, dass wir uns das mal im Detail anschauen, und für Euch mit den Forschenden sprechen? Dann teile diese Meldung und tagge @expidforschung!
Pressemitteilung
Foto: CDC
Musik: Sven Laux